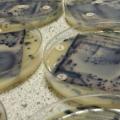
βακτήρια

Πολλά εξαρτώνται από αυτήν την κίνηση…
Βέλγοι επιστήμονες ανακάλυψαν ενδείξεις ότι μερικά βακτήρια.,..
Τα τελευταία χρόνια, δίνεται όλο και περισσότερη έμφαση στη διατήρηση της υγείας του εντέρου και, σύμφωνα με μια νέα μελέτ
Περίπου ένα στα τέσσερα φάρμακα -ανάμεσα τους πολλά που συνταγογραφούνται ευρέως- έχουν σημαντικές επιπτώσεις στις βακτηρι
Τι ζει πιο συχνά στο χώμα και στη σκόνη που πατάμε; Για πρώτη φορά οι επιστήμονες έχουν μια απάντηση στο ερώτημα αυτό, καθ
Τα πλυντήρια πιάτων των σπιτιών μπορεί να καθαρίζουν τα πιάτα και τα ίδια να λάμπουν, ιδίως αν είναι καινούρια, παρόλα αυτ
Η πρόοδος στους τρισδιάστατους εκτυπωτές είναι συνεχής και σε λίγα χρόνια μάλλον δεν...
Τα πολυπληθή βακτήρια που ζουν στο έντερο φαίνεται να παίζουν σημαντικό ρόλο στο κατά πόσο θα συρρικνωθούν οι όγκοι ενός α
Η Περιφέρεια Κρήτης σε συνεργασία με τους: ΓΕΩΤΕΕ Π.Κ.
Η Βρετανίδα εικαστική καλλιτέχνης 'Ανα Ντουμιτρίου (Anna Dumitiu) συνεχίζει να καινοτομεί...
Οι πάσχοντες από ημικρανία διαθέτουν στη στοματική τους κοιλότητα και στο γαστρεντερικό τους σύστημα περισσότερους